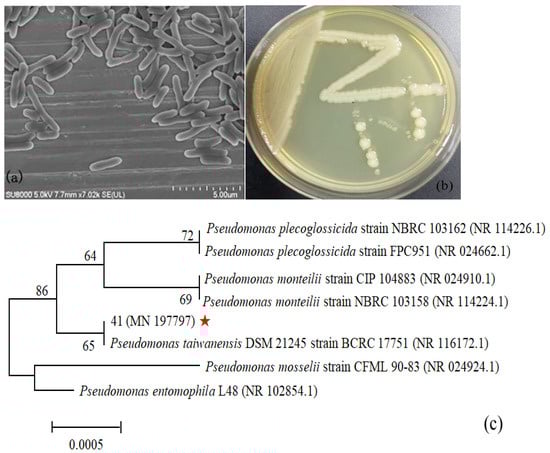

Abstract
Nitrogen pollution of surface water is the main cause of water eutrophication, and is considered a worldwide challenge in surface water treatment. Currently, the total nitrogen (TN) content in the effluent of wastewater treatment plants (WWTPs) is still high at low winter temperatures, mainly as a result of the incomplete removal of nitrate (NO3−-N). In this research, a novel aerobic denitrifier identified as Pseudomonas sp. 41 was isolated from municipal activated sludge; this strain could rapidly degrade a high concentration of NO3−-N at low temperature. Strain 41 completely converted 100 mg/L NO3−-N in 48 h at 15 °C, and the maximum removal rate reached 4.0 mg/L/h. The functional genes napA, nirS, norB and nosZ were successfully amplified, which provided a theoretical support for the aerobic denitrification capacity of strain 41. In particular, the results of denitrification experiments showed that strain 41 could perform aerobic denitrification under the catalysis of NAP. Nitrogen balance analysis revealed that strain 41 degraded NO3−-N mainly through assimilation (52.35%) and aerobic denitrification (44.02%), and combined with the gene amplification results, the nitrate metabolism pathway of strain 41 was proposed. Single-factor experiments confirmed that strain 41 possessed the best nitrogen removal performance under the conditions of sodium citrate as carbon source, C/N ratio 10, pH 8, temperature 15–30 °C and rotation speed 120 rpm. Meanwhile, the bioaugmentation test manifested that the immobilized strain 41 remarkably improved the denitrification efficiency and shortened the reaction time in the treatment of synthetic wastewater.
1. Introduction
Nitrogen is a common contaminant in water bodies, and NO3−-N is one of the important sources of nitrogen pollution. NO3−-N removal is considered an essential part of most WWTPs because it accounts for more than 70% of TN in effluent [1]. Currently, the low removal efficiency of NO3−-N is one of the main reasons for excessive TN in WWTPs. Rivers and other surface water bodies are the most important receiving water bodies for WWTPs; excessive nitrogen discharged into rivers leads to water eutrophication and the black-odorous water phenomenon, and destroys the balance of natural water ecosystems [2,3,4]. Moreover, NO3−-N increases the risk of gastric cancer, causes blue baby syndrome [5] and seriously threatens human health [6,7,8]. Thus, it is urgent to develop effective methods to remove NO3−-N in water.
Biological nitrogen removal (BNR) is considered an economical, high-efficiency and environmentally friendly wastewater treatment method [9,10,11]. In conventional BNR, biological denitrification is generally a reduction reaction process that converts NO3−-N or NO2−-N into gaseous nitrogen; it is carried out by denitrifying bacteria under anoxic conditions [12,13]. Numerous studies have demonstrated that the denitrification process is affected by many environmental factors such as carbon source types, C/N ratio, temperature, dissolved oxygen (DO) concentration and pH [14], among which temperature is an essential influencing factor. It has been proved that the optimum temperature ranges from 25 to 37 °C for most denitrifying microorganisms [15,16,17], whereas due to the geographical factors and seasonal effects the temperature of sewage treatment systems can drop to 8–15 °C or even below 5 °C in winter [18]. Temperatures deviating from the optimal condition will inhibit the growth of denitrifiers [19], decrease the expression of enzyme activities [20] and even change the community structure of functional microorganisms [18]. The above restrictions will lead to excessive nitrogen content (especially TN) in WWTP effluent, and thus directly affect the effluent quality. In project operation, parameters are adjusted (HRT, SRT) and thermal equipment is installed to enhance the nitrogen removal efficiency of microorganisms at low temperature, ultimately increasing the investment cost [20,21]. Therefore, it is a major challenge for WWTPs to overcome the limitation of low nitrogen removal efficiency in the low-temperature winter period.
Aerobic denitrification processes are driven by aerobic denitrification microorganisms and are considered a promising technology for wastewater treatment. Researchers have screened cold-tolerant aerobic denitrifying strains from different habitats (Table 1). Pseudomonas sp. is the most common aerobic denitrifying microorganism in wastewater treatment systems. Some cold-tolerant Pseudomonas bacteria have been screened out, which indicates that Pseudomonas sp. may be the dominant bacteria among cold-tolerant strains. However, the nitrogen metabolism pathway of the same strain may be different in different ecosystems. Therefore, when exogenous cold-resistant microbes are applied to sewage treatment systems, they are easily replaced by indigenous dominant bacteria due to their limited ability to adapt to the environment. To the best of our knowledge, current research on the low-temperature aerobic denitrification of sewage treatment system is relatively scarce. Thus, it is of great practical significance to screen high-efficiency, indigenous, cold-tolerant aerobic denitrification microorganisms from sewage treatment systems, and to study their denitrification characteristics at low-temperature.

Table 1.
List of cold-tolerant aerobic denitrifying bacteria reported in different environments.
In this study, Pseudomonas sp. 41, an indigenous aerobic denitrifying strain with low-temperature tolerance, was screened from aerobic activated sludge of WWTPs. The NO3−-N removal capacity and aerobic denitrification performance of strain 41 were determined at 15 °C. Specific functional genes in the aerobic denitrification process were amplified. Furthermore, the impacts of environmental factors including carbon source, C/N ratio, pH, temperature and DO concentration on the nitrogen removal capacity of strain 41 were assessed. Finally, the nitrogen removal performance of Pseudomonas sp. 41 in synthetic wastewater was examined. This study increases the number of native psychrotrophic bacteria that degrade NO3−-N under cold conditions, and provides a potential resource to solve the problem of the poor biological denitrification of cold wastewater.
2. Results and Discussion
2.1. Isolation and Identification of Strain 41
In the preliminary screening period, 40 cold-adaptive aerobic denitrification strains were isolated from activated sludge, among which strain 41 showed the highest aerobic denitrification ability and was selected for further study. Strain 41 on DM agar plate showed a slightly raised, milky white, translucent and wrinkled morphology with an irregular edge. The bacterium was Gram-negative and appeared rod-shaped with a size of 0.7 × (2.2–4.7) μm (Figure 1a). Physiological and biochemical experimental results of strain 41 are shown in Table S1 (Supplementary Materials). The partial 16S rRNA gene sequence of strain 41 was submitted to GenBank and it was assigned the accession number MN197797. The BLAST results revealed that strain 41 was closest to Pseudomonas taiwanensis DSM 21245, with a high similarity of 99%. A neighbor-joining phylogenetic tree was constructed based on the 16S rRNA sequence of strain 41 and other phylogenetically related strains (Figure 1b). The above results indicated that strain 41 was affiliated to the genus Pseudomonas and was named as Pseudomonas sp. 41. The strain was preserved in the China General Microbiological Culture Collection Center (CGMCC No. 24230).
Figure 1.
Identification of strain 41: (a) SEM image; (b) colony characteristics; (c) phylogenetic tree of strain 41 based on 16S rRNA gene sequence, ★ represented strain 41.
2.2. Functional Genes Involved in Denitrification
In order to clarify the potential aerobic denitrification performance of strain 41, the key functional genes, including napA, nirS, nirK, norB and nosZ, were amplified and evaluated. The PCR results are shown in Figure 2. The 877 bp gene fragment of napA, encoding periplasmic nitrate reductase (NAP), was found to be amplified in strain 41. The main function of NAP is to catalyze the conversion of nitrate to nitrite under aerobic conditions. napA has been widely regarded as a functional marker to identify aerobic denitrification strains [15]. The napA gene was also found to be amplified in Acinetobacter sp. strain C-13 [28], Bacillus JD-014 [29], Marinobacter hydrocarbonoclasticus RAD-2 [30] and Pseudomonas mendocina strain GL6 [31]. About 890 bp of the nirS gene fragment was obtained, but the nirK was not amplified. The nirS and nirK genes encode nitrite reductase (NIR), which converts nitrite into nitric oxide [32]; these genes have also been commonly used as molecular markers for aerobic denitrification, and therefore the obtained result indicated that strain 41 was a nirS-type denitrifier. Meanwhile, the PCR results suggested the presence of another two key genes, namely norB and nosZ, with lengths of 1645 bp and 1675 bp, respectively. Nitric oxide reductase (NORB) is encoded by the norB gene and catalyzes the reduction of NO to N2O [33]. NOS is encoded by the nosZ gene and is involved in the conversion N2O to N2 [33,34]. The coexistence of the above genes provided theoretical evidence that strain 41 possessed the potential for complete denitrification.

Figure 2.
Amplification of functional genes involved in denitrification in strain 41.
2.3. Aerobic Denitrification Capability of Strain 41
The growth characteristics and aerobic denitrification capacity of strain 41 were assessed when NO3−-N was supplied as the sole nitrogen source. The fitting result of the growth curve with Slogistic1 equation is shown in Figure 3a. The coefficient of correlation (R2) was 0.99, indicating that the equation fully described the actual growth characteristics of strain 41. The values of a, k and xc were 1.42, 0.20 and 25.40, respectively. Hence, the maximum cell growth rate of strain 41 was 0.20 h−1, which was slightly lower than that of Pseudomonas stutzeri strain XL-2 (0.31 h−1) at 30 °C [35]. This difference may have been caused by the different culture temperatures—that is, the low temperature slowed the growth rate of strain 41 [36]. As shown in Figure 3a, the lag phase was from 0 to 12 h and the OD600 value increased from 0.062 to 0.120. This lies in contrast to Janthinobacterium sp. M-11, which showed a short adaptation period (5 h) but low biomass (OD600 = 0.06) at 2 °C [37]; and different from Acinetobacter sp. ND7, which did not undergo a lag phase but directly entered the logarithmic phase at 28 °C [38]. The longer lag phase of strain 41 may have been due to the low-temperature environment, the amount of bacteria inoculation and the type of culture medium. After the lag phase, strain 41 entered the logarithmic growth phase between 12 and 36 h with an average growth rate of 0.051 h−1. Following this the strain entered the steady phase; the maximum growth abundance reached 1.36 at 40 h.

Figure 3.
Nitrogen removal characteristics of strain 41: (a) growth curve of strain 41; (b) concentration changes of NO3−-N, NO2−-N, NH4+-N and DTN of strain 41 at 15 °C; (c) NO3−-N and DTN removal efficiency at 15 °C.
The aerobic denitrification ability of strain 41 at 15 °C was tested using NO3−-N as the sole nitrogen source with an initial concentration about 100 mg/L. As shown in Figure 3b,c, the high consumption of NO3−-N was consistent with the rapid proliferation of bacteria; approximately 89.4% NO3−-N was depleted in the first 36 h, and the maximum NO3−-N removal rate was up to 4.0 mg/L/h between 20 and 24 h. Subsequently, the NO3−-N concentration continued to decrease and it was completely removed at 48 h. During the cultivation process, the average removal rate of NO3−-N was 2.13 mg/L/h at 15 °C—higher than denitrifiers Pseudomonas sp. Y39-6 at 20 °C (1.77 mg/L/h) and K. variicola strain sd-3 at 30 °C (1.14 mg/L/h), which were cultivated in aerobic denitrification medium with initial NO3−-N concentrations of 50 mg/L and 40 mg/L, respectively [26,39]. By comparison, it was found that strain 41 had excellent aerobic denitrification ability at low temperature.
It is well known that NO2−-N is the main intermediate metabolite of NO3−-N reduction in the denitrification process. Figure 3b shows that the NO2−-N concentration reached the peak of 3.87 mg/L at 20 h, further confirming that strain 41 reduced NO3−-N to NO2−-N, and then NO2−-N was completely removed at 48 h, suggesting the presence of nitrite reductase in strain 41. This phenomenon was consistent with observations of Pseudomonas putida Y-12 [40] and Pseudomonas sp. DM02 [41], while it was quite different from the results obtained for Pseudomonas bauzanensis DN13-1 [42] and Pseudomonas mendocina X49 [43], in which no obvious NO2−-N was detected. Other strains such as Acinetobacter sp. TAC-1 [20] and Pseudomonas stutzeri T13 [44] exhibited higher NO2−-N accumulation during denitrification. Several studies have indicated that the presence of NO2−-N may reduce TN removal efficiency, poison microorganisms and inhibit cell activity [38,45,46]. Thus, strain 41 could be an excellent candidate without NO2−-N accumulation in low-temperature aerobic denitrification.
The removal trends of DTN and NO3−-N were consistently high; about 92.74% of DTN was removed at the end of the degradation (Figure 3c). In addition, the DTN removal efficiency of strain 41 at 15 °C was higher than that of Acinetobacter sp. YS2 (80.36%) at 20 °C [47] and Ochrobactrum anthropi HND19 (73.4%) at 30 °C [48]. During the denitrification process, NH4+-N was always maintained at a low level of approximately 0.5–0.7 mg/L; the release of NH4+-N from the broken bacteria could explain this phenomenon.
2.4. Nitrate Metabolic Pathways of Strain 41
The denitrification pathway of strain 41 under low-temperature, aerobic conditions was analyzed by calculating the concentrations of various forms of nitrogen in the reaction system, with NO3−-N as the sole nitrogen source. Nitrogen balance analysis results showed that 52.35% of initial nitrogen was used for cell synthesis through assimilation, 44.02% was converted into gaseous nitrogen and about 6.71% nitrogen loss was observed, which was possibly contributed by other dissolved nitrogen and measurement errors (Table 2). The gaseous N products indicated that strain 41 could perform aerobic denitrification at 15 °C, but the types of gaseous N need further study. Furthermore, the experimental results further validated that strain 41 possessed excellent denitrification characteristics and no NO2−-N accumulation. These results indicated that the nitrate metabolism of strain 41 was unlike that of Pseudomonas stutzeri XL-2 [35] and Pseudomonas balearica RAD-17 [49], which transfer nitrate to gaseous N preferentially; it was also different from that of Vibrio sp. Y1-5, for which the nitrate removal pathway [50] was assimilatory nitrate reduction. Combined with the successful amplification of denitrifying functional genes of napA, nirS, norB and nosZ, it could be preliminarily deduced that the aerobic denitrification metabolic pathway of strain 41 was NO3−-N → NO2−-N → NO → N2O → N2.

Table 2.
Nitrogen balance of Pseudomonas sp. 41 during the denitrification process under aerobic conditions.
2.5. Effects of Single Factors on the Denitrification Characteristics of Strain 41
2.5.1. Carbon Source
Aerobic denitrification is essentially a redox process. The carbon source is not only used as a substrate for microbial growth, but also serves as an electron donor for denitrifying bacteria [51]. Previous research concluded that different organic carbon sources have different redox potentials [52], so the utilization rates of bacteria to different carbon sources are also dissimilar. As shown in Figure 4, the growth curves and NO3−-N removal efficiency of strain 41 were significantly affected by the type of carbon source. Strain 41 exhibited higher biomass and nitrogen removal efficiency when sodium citrate or sodium succinate was the carbon source than those observed when sodium acetate and glucose were the carbon source (Figure 4a,b); after incubation for 48 h at 15 °C the NO3−-N removal efficiencies were 100%, 97.89%, 64.28% and 79.49%, respectively (Figure 4c). Meanwhile, the highest DTN removal efficiency (91.00 %) was observed when sodium citrate was used as a carbon source (Figure 4d). The results were consistent with those obtained for Pseudomonas stutzeri T1 [53] and Pseudomonas mendocina S16 [54]. This phenomenon is mainly attributed to the simple molecular structure of sodium citrate, which allows it to easily enter the denitrification metabolic process [55]. In addition, citric acid can directly participate in the tricarboxylic acid cycle (TCA), an efficient aerobic respiration productivity pathway [54,56,57]. Considering the economic performance and nitrogen removal performance, sodium citrate was selected as the optimal carbon source in subsequent experiments.

Figure 4.
Nitrogen removal characteristics of strain 41 under different carbon sources: (a) growth curves of strain 41; (b) variation of NO3−-N concentration; (c) removal efficiency of NO3−-N; (d) characteristics of DTN removal.
2.5.2. C/N Ratio
In the process of aerobic denitrification, the amount of organic carbon is a key factor affecting cell growth and nitrogen removal efficiency [58]. The effect of C/N ratio on the growth of strain 41 is shown in Figure 5a. Obviously, the high concentration of organic carbon contributed to the growth of strain 41, probably because sufficient carbon source provided enough energy for cell growth and served as the carbon skeleton of cell structure. Similar results were also found in Marinobacter strain NNA5 and Pseudomonas stutzeri YG-24 [52,59]. As shown in Figure 5b,c, the NO3−-N was almost completely removed within 48 h when the C/N ratios were in the range of 10–15, and the NO3−-N removal efficiency dropped slightly to 94.98% at C/N of 20. For lower C/N ratios of 1–5, the denitrification performance was significantly reduced because the low C/N ratio could not supply sufficient energy or electron donors for microbial growth [41,60,61]. Furthermore, the removal efficiency of NO3−-N was also inhibited with the further increase of C/N ratio to 30; this could be because excessive organic carbon can directly enter into the enzyme structure and affect the enzyme activity, inhibiting the cell growth and metabolism of strain 41 [61]. As for DTN, it can be seen from Figure 5d that an organic loading that is either too high or too low exerted a negative impact on the DTN removal owing to the accumulation of NO3−-N. Considering that excessive C/N would also cause an unnecessary waste of carbon sources, C/N 10 was selected as the optimal C/N for strain 41 at low temperature. Notably, the C/N ratio in WWTPs is generally not high; this result indicated that strain 41 has a great application prospect in real-world engineering applications.

Figure 5.
Effect of C/N ratios on aerobic denitrification of strain 41. (a) Growth curves of strain 41; (b) variation of NO3−-N concentration; (c) removal efficiency of NO3−-N; (d) characteristics of DTN removal.
2.5.3. Initial pH
The pH condition has a significant influence on bacterial activity. The primary role of pH is to cause a change in the charge of the cell membrane, thus affecting the microbial absorption of nutrients and further affecting the growth and reproduction of microorganisms [62]. The influence of the initial pH on the growth and nitrogen degradation of strain 41 is shown in Figure 6a,b. An obvious inhibition was observed on the denitrification at pH 5—strain 41 could not grow and no nitrogen removal was observed. The primary reason was that extreme pH damages cells and inhibits metabolism [62]. Under the optimum pH of 8, the biomass of strain 41 was the highest (OD600 was 1.42), and the removal efficiencies of NO3−-N and DTN were 100% and 93.08%, respectively (Figure 6c,d). Strain 41 exhibited excellent growth and denitrification characteristics at pH 7–9, which was consistent with previous studies that neutral and slightly alkaline conditions were usually beneficial for the growth of most denitrifying bacteria [14,63,64]. According to the results, pH 8 was selected as the optimal pH for the growth and denitrification of strain 41 in further experiments.

Figure 6.
Effect of initial pH on nitrogen removal by strain 41. (a) Growth curves of strain 41; (b) variation of NO3−-N concentration; (c) removal efficiency of NO3−-N; (d) characteristics of DTN removal.
2.5.4. Temperature
Temperature is critical to bacterial growth and metabolism [65]. The influence of temperature on the growth and aerobic denitrification properties of strain 41 were determined. Figure 7a–c illustrate that in the range of 15–30 °C, the higher temperature was beneficial to the growth and denitrification efficiency of strain 41. Interestingly, however, there were no significant differences in the biomass or nitrate removal efficiency of strain 41 at 15 °C, 20 °C and 30 °C for 48 h, which were 1.23–1.39 and 100%, respectively. Meanwhile, the DTN removal efficiency at 15 °C was slightly lower than that at 20 °C and 30 °C (Figure 7d). Considering that there was no significant difference in biomass and no obvious accumulation of NO3−-N, NO2−-N or NH4+-N, we speculated that other forms of nitrogen compounds may have existed at low temperature. After the overall consideration, strain 41 showed excellent removal efficiencies of NO3−-N (100%) and DTN (>92%) in the range of 15–30 °C, which indicated that strain 41 possessed wider temperature adaptation compared with most of the reported aerobic denitrifiers working at normal temperature [41,66,67]. Hence, strain 41 has great application prospects in WWTPs in different seasons.

Figure 7.
Effect of temperature on nitrogen removal performance of strain 41. (a) Growth curves of strain 41; (b) variation of NO3−-N concentration; (c) removal efficiency of NO3−-N; (d) characteristics of DTN removal.
2.5.5. DO
Most of the currently known aerobic denitrifying microorganisms are facultative anaerobic bacteria, and different strains conduct different oxygen metabolic pathways [68]. The optimal DO of strain 41 was preliminarily studied by adjusting rotational speed. Strain 41 showed the best growth rate and NO3−-N removal efficiency at 120 rpm (Figure 8a,b). Figure 8c summarizes the variations of NO3−-N removal: the NO3−-N removal efficiency was 98.72% when the shaking speed was 90 rpm (DO was 5.4 mg/L), the highest NO3−-N removal efficiency (100%) was obtained at 120 rpm (DO was 6.9 mg/L) and the NO3−-N removal efficiency slightly decreased to 97.70% as the speed was further increased to 150 rpm (DO was 7.6 mg/L). However, compared with 120 rpm shaking, DTN removal efficiencies at 90 rpm and 150 rpm dramatically decreased, reaching 94.33%, 72.54% and 80.41%, respectively (Figure 8d). These results demonstrated that the appropriate increase of DO concentration was favorable to accelerate the mass transfer of oxygen molecules and pollutants, enhance the enzyme activity and promote the contact between strain 41 and pollutants [35]. However, it was found that the excessive DO level would restrict the denitrification effect, likely because some oxygen-sensitive enzymes (e.g., nitrite reductase) may be inactivated gradually under highly aerobic conditions [68]. Analogously, the relationship between DO and denitrification characteristics also appeared in Acinetobacter sp. T1 [69] and Ochrobactrum anthropi HND19 [48]. As a result, 120 rpm was chosen as the optimal shaking speed for nitrogen removal by strain 41.

Figure 8.
Effect of DO on nitrogen removal performance of strain 41. (a) Growth curves of strain 41; (b) variation of NO3−-N concentration; (c) removal efficiency of NO3−-N; (d) removal characteristics of DTN.
2.6. Application Performance Evaluation of Pseudomonas sp. 41 in Wastewater Treatment
The aerobic denitrification performance of immobilized strain 41 at low temperature was studied. Figure 9a showed that the NO3−-N removal efficiencies of Pm. 41 with carrier and Pm. 41 without carrier were respectively 95.08 % and 81.63% after 32 h culture at 15 °C, and reached 96.46% and 95.17%, respectively, after 48 h. These results indicated that the denitrification efficiency of immobilized strain 41 was significantly improved under the same inoculation, and the denitrification time was effectively shortened. The main explanations for the above results include: (1) the biomass increases significantly as the carriers provide sufficient surface area for the growth and reproduction of microorganisms [18]; (2) biofilm systems have stronger resistance to low-temperature environments [26]; (3) biofilm systems exhibit better material exchange capacity [70]; and (4) extracellular polymeric substances (EPSs), the primary component of biofilm systems, can increase the stability of microbial community structure [71]. For NO2−-N, the accumulation was not significant (<1.0 mg/L) in either the experimental group or the control group. As shown in Figure 9b, Pm. 41 with carrier achieved the maximum TN removal efficiency of 78%, while it was only 36.76% in the Pm. 41 without carrier. The average removal rates of TN achieved in the Pm. 41 with carrier and Pm. 41 without carrier were 0.45 mg/L/h and 0.22 mg/L/h, respectively. There are two main reasons for the above results: (1) the higher accumulation of NO3−-N in the blank group; (2) the bacterial liquid of the bioaugmentation group was cleaner than that of the blank group, indicating that more microorganisms were attached to the carrier filler in the biofilm state, while the microorganisms in the blank group were in the planktonic state, so the contribution of intracellular nitrogen was also one of the crucial factors. The research results proved that the immobilization of strain 41 is an effective bioaugmentation strategy for denitrification at low temperature, which had the advantages of high nitrogen removal efficiency and low sludge production.

Figure 9.
Nitrogen removal characteristics of strain 41. (a) Changes of NO3−-N and NO2−-N concentrations in experimental group and control group; (b) removal efficiency of TN in the experimental group and control group.
3. Materials and Methods
3.1. Media
Luria-Bertani (LB) medium was used for the expanded culture of strains, and contained 10 g/L peptone, 5 g/L yeast extract and 10 g/L NaCl.
Enrichment medium (EM) was used for the bacterial enrichment culture and the components were as follows: 0.5 g/L (NH4)2SO4; 0.36 g/L KNO3; 4.0 g/L sodium citrate; and 0.5 mL/L trace element solution consisting of 6.5 g/L K2HPO4·3H2O, 2.5 g/L MgSO4·7H2O, 2.5 g/L NaCl, 0.05 g/L FeSO4·7H2O and 0.04 g/L MnSO4·H2O.
Denitrification medium (DM) used for bacteria isolation and denitrification ability evaluation, contained: 0.72 g/L KNO3, 10.55 g/L Na2HPO4·12H2O, 1.5 g/L KH2PO4, 0.1 g/L MgSO4·7H2O, 4.08 g/L sodium citrate and 2 mL/L trace element solution. The trace element solution contained the following ingredients: 50.0 g/L EDTA-2Na, 2.2 g/L ZnSO4, 5.5 g/L CaCl2, 5.06 g/L MnCl2·4H2O, 5.0 g/L FeSO4·7H2O, 1.57 g/L CuSO4·5H2O and 1.61 g/L CoCl2·6H2O.
Bromothymol Blue (BTB) medium was adopted to preliminarily screen denitrifying bacteria; the components were as follows: 1.0 g/L KNO3, 8.5 g/L sodium citrate, 1.0 g/L L-asparagine, 1.0 g/L KH2PO4, 1.0 g/L MgSO4·7H2O, 0.2 g/L CaCl2·6H2O, 0.05 g/L FeCl3·6H2O, 1 mL BTB dissolved by 1% (w/v) ethanol solution and 15 g agar powder.
Artificial synthetic wastewater (ASW) was used to verify the denitrification performance of strain 41 in wastewater treatment, and its components were as follows: 0.817 g/L C6H5Na3O7·2H2O, 0.144 g/L KNO3, 0.0442 g/L K2HPO4·3H2O, 0.0264 g/L KH2PO4, 0.205 g/L MgSO4·7H2O, 0.0441 g/L CaCl2·2H2O and 0.4 mL/L trace element solution. The trace element solution contained: 0.14 g/L KI, 0.1 g/L H3BO3, 0.02 g/L CuSO4·5H2O, 0.09 g/L MnCl2·4H2O, 1.0 g/L FeCl3·6H2O, 0.045 g/L Na2MoO4·2H2O, 0.1 g/L CoCl2·6H2O, 7.5 g EDTA-2Na and 0.09 g/L ZnSO4·7H2O.
The final pH of the above media was adjusted to 7.0, and all media were autoclaved at 121 °C for 30 min.
3.2. Isolation and Identification of Aerobic Denitrifiers
The activated sludge samples were collected from the Qiaodong WWTP of Shijiazhuang in China. The sludge sample was transferred into 250 mL sterilized EM at 10% volume ratio and incubated at 15 °C and 150 rpm for 30 days. In the enrichment stage, the fresh EM was replaced according to the volume ratio of 10% every 24 h. Then, 25 mL of the enriched bacterial suspension was inoculated into 500 mL conical flask containing 250 mL DM and cultivated at 15 °C and 150 rpm for 14 days, and changed 25 mL fresh DM per 24 h. After 14 days of incubation, the samples were streaked on DM agar plates by the gradient dilution method and cultured at 15 °C until visible colonies formed. Colonies with different morphological characteristics were selected and purified by streaking on DM agar plates until the pure strain was obtained. Then, single colonies were inoculated onto BTB medium plates for rescreening; the strains that could turn BTB medium from green to blue were selected and their denitrification performance was tested. Strain 41 with the highest denitrification ability was selected for further analysis.
The genomic DNA of isolated strain 41 was extracted with the CTAB method [72]. The 16S rRNA sequence of strain 41 was amplified by PCR using universal primers 27F and 1492R [73] and sequenced by RuiBiotech Co., Ltd. (Beijing, China). The obtained sequence was compared with available 16S rRNA sequences in NCBI by BLAST (http://blast.ncbi.nlm.nih.gov/Blast.cgi, accessed on 26 July 2019) and the sequence of strain 41 was submitted to GenBank and obtained the accession number (MN197797). A phylogenetic tree was constructed using MEGA 7.0 by the neighbor-joining method.
3.3. PCR Amplification of Functional Genes Involved in Denitrification
To confirm the presence of functional genes involved in denitrification in strain 41, genes encoding periplasmic nitrate reductase (napA), nitrite reductases (nirS and nirK), nitric oxide reductase (norB) and nitrous oxide reductase (nosZ) were detected by PCR (Bioer, Hangzhou, China). The genomic DNA of strain 41 was used as template; the specific primers are listed in Table S2 (Supplementary Materials) and the PCR amplification procedures are listed in Table S3 (Supplementary Materials). The PCR products were analyzed by 2% agarose gel electrophoresis (Liuyi Inc., Beijing, China).
3.4. Assessment of Aerobic Denitrification Capacity of Strain 41
To investigate the aerobic denitrification performance of strain 41 at low temperature, strain 41 was incubated in LB medium at 15 °C with a shaking speed of 150 rpm for 24 h to obtain the seed culture. The bacteria pellets were harvested by centrifugation (5000 rpm, 4 °C for 5 min) and washed with sterilized ddH2O three times to purify the bacterial suspension. Then, the seed culture was inoculated into 250 mL conical flasks containing 100 mL DM at 1% (v/v), and the flasks were shaken at 150 rpm at 15 °C for 48 h. Samples were withdrawn every 4 h to determine OD600, NH4+-N, NO3−-N, NO2−-N, dissolved TN (DTN) and TN. All experiments were carried out in triplicate.
3.5. Effects of Single Factors on Aerobic Denitrification Performance of Strain 41
Single-factor experiments were designed to explore the aerobic denitrification performance of strain 41 under different culture conditions; the variables were carbon source, C/N ratio, pH, temperature and DO. To clarify the optimal carbon source of strain 41, sodium citrate, sodium succinate, sodium acetate and glucose were used as the sole carbon source separately. In the experiment evaluating the effect of C/N ratio, the C/N ratios were adjusted to 1, 5, 10, 15, 20 and 30 with the fixed NO3−-N concentration of 100 mg/L. For the pH experiment, the initial pH was adjusted to 5, 6, 7, 8 or 9. To detect the effect of temperature on nitrogen removal, the experiment was conducted at 15, 20 and 30 °C. Additionally, the effect of DO concentration on NO3−-N removal was conducted by changing the shaking speed to 90, 120 and 150 rpm, and the corresponding DO concentrations were 5.4, 6.9 and 7.6 mg/L, respectively. In all the experiments, 1% (v/v) seed suspension of strain 41 was inoculated into 100 mL DM. The preconditions of all denitrification media were fixed (15 °C, 150 rpm, pH 7 and C/N ratio 10) unless the single factor was adjusted as described in the above experimental design. The samples were taken periodically and indicators of OD600, NO3−-N and DTN were detected. All single experiments were carried out in triplicate.
3.6. Application of Strain 41 in Wastewater Treatment
In order to explore the application mode and denitrification efficiency of strain 41 in sewage treatment at low temperature, seed suspensions of strain 41 were collected according to Section 3.4. and inoculated into synthetic wastewater with an initial NO3−-N concentration of 20 mg/L. In the test group, strain 41 was inoculated into 250 mL sterilized ASW and 1% (v/v) of sterilized polypropylene fiber (PP) was added as the carrier for strain 41 to form biofilm (named as Pm. 41 with carrier). The reaction system without PP was set as the control group (named as Pm. 41 without carrier). Both the experimental group and the control group were operated at 15 °C and 120 rpm for 48 h. Sampling analysis was performed every 8 h to monitor the concentration of NO3−-N, NO2−-N and TN. All experiments were conducted in triplicate.
3.7. Analysis Methods of Physical and Chemical Indicators
Cell density was tested by measuring the absorbance at 600 nm (OD600) with a spectrophotometer (Thermo Fisher Scientific, Massachusetts, USA). NH4+-N concentration was assessed by the method of Nessler’s reagent photometry, NO3−-N was measured using ultraviolet spectrophotometry (Thermo Fisher Scientific, Massachusetts, USA), NO2−-N was estimated by N-(1-naphthalene)-diaminoethane spectrophotometry, and TN and DTN were determined via alkaline potassium persulfate digestion-ultraviolet spectrophotometry (Thermo Fisher Scientific, Massachusetts, USA). The determination methods of nitrogen were based on State Environmental Protection Administration of China (Beijing, China, 2012). DO was measured with a water quality meter (INESA, Shanghai, China), pH value was measured with a pH meter (Mettler Toledo, Schwerzenbach, Switzerland) and SEM was carried out by Science Compass Co. Ltd. (Jinan, China) using a HITACHI SU8010 instrument.
Removal efficiencies and removal rates of nitrogen were calculated according to the following equations:
where RE and RR represent nitrogen removal efficiency and removal rate, C0 is the initial concentration of nitrogen substances, Ct represents the concentration at a given time and t represents reaction time.
The growth curve of strain 41 was fitted with the Slogistic1 equation, as follows:
where parameter a represents the maximum OD600, k indicates the maximum growth rate, xc indicates half of the time required to reach the maximum OD600 and x is the cultivation time.
The nitrogen balance analysis was conducted according to a previous study [74].
4. Conclusions
Pseudomonas sp. 41 was isolated from municipal activated sludge and presented great aerobic denitrification capability at 15 °C. The successful amplification of denitrification genes napA, nirS, norB and nosZ confirmed that strain 41 had the potential to carry out the complete denitrification process. Moreover, combined with nitrogen balance analysis, the aerobic denitrifying metabolic pathway of strain 41 at low temperature was . The optimal denitrification conditions of strain 41 were sodium citrate as the carbon source, C/N ratio of 10, pH 8, temperature of 15–30 °C and rotating speed of 120 rpm (DO 6.9 mg/L), demonstrating that strain 41 had a strong adaptability to temperature. In addition, the immobilization of strain 41 was proved to be an effective application method, which obviously increased the denitrification efficiency at low temperature. Taken together, the results suggest that Pseudomonas sp. 41 has great resistance to low temperature and demonstrates high nitrate removal efficiency. It could be used as an excellent candidate strain for denitrification in WWTPs under low-temperature conditions.
Supplementary Materials
The following supporting information can be downloaded at: https://www.mdpi.com/article/10.3390/catal12040412/s1, Table S1: Physiological and biochemical properties of strain 41; Table S2: Primer sequences of denitrification genes; Table S3: PCR procedures of denitrification genes.
Author Contributions
Conceptualization, B.W. and P.L.; methodology, B.W.; software, B.W.; validation, P.L., B.W. and W.M.; formal analysis, B.W.; investigation, P.L. and B.W.; resources, X.L.; data curation, B.W.; writing—original draft preparation, P.L. and B.W.; writing—review and editing, P.L. and B.W.; visualization, B.W.; supervision, P.L. and X.L.; project administration, P.L.; funding acquisition, X.L. and P.L. All authors have read and agreed to the published version of the manuscript.
Funding
This research was funded by Hebei University of Science and Technology No. 1181374, Hebei Education Department No. ZD2017233 and Hebei Provincial Department of Science and Technology No. 21373904D.
Data Availability Statement
The data presented in this study are openly available in the NCBI. The accession number has been listed in the article.
Acknowledgments
The authors thank the Pollution Prevention Biotechnology Laboratory of Hebei Province for supporting this work.
Conflicts of Interest
The authors declare no conflict of interest.
References
- Cao, J.; Zhang, T.; Wu, Y.; Sun, Y.; Zhang, Y.; Huang, B.; Fu, B.; Yang, E.; Zhang, Q.; Luo, J. Correlations of nitrogen removal and core functional genera in full-scale wastewater treatment plants: Influences of different treatment processes and influent characteristics. Bioresour. Technol. 2020, 297, 122455. [Google Scholar] [CrossRef] [PubMed]
- Shi, Z.; Zhang, Y.; Zhou, J.; Chen, M.; Wang, X. Biological removal of nitrate and ammonium under aerobic atmosphere by Paracoccus versutus LYM. Bioresour. Technol. 2013, 148, 144–148. [Google Scholar] [CrossRef] [PubMed]
- Ahn, Y.-H. Sustainable nitrogen elimination biotechnologies: A review. Process Biochem. 2006, 41, 1709–1721. [Google Scholar] [CrossRef]
- Yao, R.; Yuan, Q.; Wang, K. Enrichment of denitrifying bacterial community using nitrite as an electron acceptor for nitrogen removal from wastewater. Water 2019, 12, 48. [Google Scholar] [CrossRef] [Green Version]
- Lv, P.; Luo, J.; Zhuang, X.; Zhang, D.; Huang, Z.; Bai, Z. Diversity of culturable aerobic denitrifying bacteria in the sediment, water and biofilms in Liangshui River of Beijing, China. Sci. Rep. 2017, 7, 10032. [Google Scholar] [CrossRef] [Green Version]
- Kerkhof, L. A species-specific probe and a PCR assay for the marine bacterium, Pseudomonas stutzeri strain Zobell. Microb. Ecol. 1994, 27, 201–212. [Google Scholar] [CrossRef]
- Su, L.; Li, K.; Zhang, H.; Fan, M.; Ying, D.; Sun, T.; Wang, Y.; Jia, J. Electrochemical nitrate reduction by using a novel Co3O4/Ti cathode. Water Res. 2017, 120, 1–11. [Google Scholar] [CrossRef]
- Dolejš, I.; Stloukal, R.; Rosenberg, M.; Rebroš, M. Nitrogen removal by co-immobilized anammox and ammonia-oxidizing bacteria in wastewater treatment. Catalysts 2019, 9, 523. [Google Scholar] [CrossRef] [Green Version]
- Ni, H.; Arslan, M.; Wei, J.; Dai, J.; Luo, Z.; Cai, R.; Zhao, S.; Gamal El-Din, M.; Wu, Z. Treatment of printing and dyeing wastewater in biological contact oxidation reactors comprising basalt fibers and combination fillers as bio-carriers: Elucidation of bacterial communities and underlying mechanisms. Sci. Total Environ. 2021, 785, 147272. [Google Scholar] [CrossRef]
- Liu, R.; Li, S.; Gao, X.; Yu, N.; Zhao, C.; Gao, C.; Lv, W. Single and combined impacts of nickel and cadmium on the performance, microbial community and enzymatic activity of sequencing batch reactors. Sci. Total Environ. 2020, 727, 138571. [Google Scholar] [CrossRef]
- Barua, V.B.; Munir, M. A review on synchronous microalgal lipid enhancement and wastewater treatment. Energies 2021, 14, 7687. [Google Scholar] [CrossRef]
- Zumft, W.G. Cell biology and molecular basis of denitrification. Microbiol. Mol. Biol. Rev. 1997, 61, 533–616. [Google Scholar] [CrossRef] [PubMed]
- Chen, T.; Yang, X.; Sun, Q.; Hu, A.; Qin, D.; Li, J.; Wang, Y.; Yu, C.-P. Changes in wastewater treatment performance and the microbial community during the bioaugmentation of a denitrifying Pseudomonas strain in the low carbon–nitrogen ratio sequencing batch reactor. Water 2022, 14, 540. [Google Scholar] [CrossRef]
- Song, T.; Zhang, X.; Li, J.; Wu, X.; Feng, H.; Dong, W. A review of research progress of heterotrophic nitrification and aerobic denitrification microorganisms (HNADMs). Sci. Total Environ. 2021, 801, 149319. [Google Scholar] [CrossRef]
- Huang, T.; Guo, L.; Zhang, H.; Su, J.; Wen, G.; Zhang, K. Nitrogen-removal efficiency of a novel aerobic denitrifying bacterium, Pseudomonas stutzeri strain ZF31, isolated from a drinking-water reservoir. Bioresour. Technol. 2015, 196, 209–216. [Google Scholar] [CrossRef]
- Rajta, A.; Bhatia, R.; Setia, H.; Pathania, P. Role of heterotrophic aerobic denitrifying bacteria in nitrate removal from wastewater. J. Appl. Microbiol. 2020, 128, 1261–1278. [Google Scholar] [CrossRef]
- Li, D.; Liang, X.; Jin, Y.; Wu, C.; Zhou, R. Isolation and nitrogen removal characteristics of an aerobic heterotrophic nitrifying-denitrifying bacterium, Klebsiella sp. TN-10. Appl. Biochem. Biotech. 2018, 188, 540–554. [Google Scholar] [CrossRef]
- Zhou, H.; Li, X.; Xu, G.; Yu, H. Overview of strategies for enhanced treatment of municipal/domestic wastewater at low temperature. Sci. Total Environ. 2018, 643, 225–237. [Google Scholar] [CrossRef]
- He, T.; Ye, Q.; Sun, Q.; Cai, X.; Ni, J.; Li, Z.; Xie, D. Removal of nitrate in simulated water at low temperature by a novel psychrotrophic and aerobic bacterium, Pseudomonas taiwanensis Strain J. BioMed Res. Int. 2018, 2018, 4984087. [Google Scholar] [CrossRef] [Green Version]
- Zhao, T.; Chen, P.; Zhang, L.; Zhang, L.; Gao, Y.; Ai, S.; Liu, H.; Liu, X. Heterotrophic nitrification and aerobic denitrification by a novel Acinetobacter sp. TAC-1 at low temperature and high ammonia nitrogen. Bioresour. Technol. 2021, 339, 125620. [Google Scholar] [CrossRef]
- Zha, X.; Ma, J.; Lu, X. Use of a low-cost and energy-efficient device for treating low-strength wastewater at low temperatures focusing on nitrogen removal and microbial community. Sci. Total Environ. 2020, 722, 137916. [Google Scholar] [CrossRef] [PubMed]
- Zheng, Z.; Zhang, D.; Li, W.; Qin, W.; Huang, X.; Lv, L. Substrates removal and growth kinetic characteristics of a heterotrophic nitrifying-aerobic denitrifying bacterium, Acinetobacter harbinensis HITLi7T at 2 °C. Bioresour. Technol. 2018, 259, 286–293. [Google Scholar] [CrossRef] [PubMed]
- Yang, Q.; Yang, T.; Shi, Y.; Xin, Y.; Zhang, L.; Gu, Z.; Li, Y.; Ding, Z.; Shi, G. The nitrogen removal characterization of a cold-adapted bacterium: Bacillus simplex Hb. Bioresour. Technol. 2021, 323, 124554. [Google Scholar] [CrossRef] [PubMed]
- Huang, X.; Weisener, C.G.; Ni, J.; He, B.; Xie, D.; Li, Z. Nitrate assimilation, dissimilatory nitrate reduction to ammonium, and denitrification coexist in Pseudomonas putida Y-9 under aerobic conditions. Bioresour. Technol. 2020, 312, 123597. [Google Scholar] [CrossRef]
- Guo, Y.; Wang, Y.; Zhang, Z.; Huang, F.; Chen, S. Physiological and transcriptomic insights into the cold adaptation mechanism of a novel heterotrophic nitrifying and aerobic denitrifying-like bacterium Pseudomonas indoloxydans YY-1. Int. Biodeter. Biodegr. 2018, 134, 16–24. [Google Scholar] [CrossRef]
- Zhang, D.; Liu, Y.; Han, Y.; Zhang, Y.; Jia, X.; Li, W.; Li, D.; Jing, L. Nitrate removal from low C/N wastewater at low temperature by immobilized Pseudomonas sp. Y39-6 with versatile nitrate metabolism pathways. Bioresour. Technol. 2021, 326, 124794. [Google Scholar] [CrossRef]
- Yang, M.; Lu, D.; Qin, B.; Liu, Q.; Zhao, Y.; Liu, H.; Ma, J. Highly efficient nitrogen removal of a coldness-resistant and low nutrient needed bacterium, Janthinobacterium sp. M-11. Bioresour. Technol. 2018, 256, 366–373. [Google Scholar] [CrossRef]
- Chen, H.; Zhou, W.; Zhu, S.; Liu, F.; Qin, L.; Xu, C.; Wang, Z. Biological nitrogen and phosphorus removal by a phosphorus-accumulating bacteria Acinetobacter sp. strain C-13 with the ability of heterotrophic nitrification-aerobic denitrification. Bioresour. Technol. 2021, 322, 124507. [Google Scholar] [CrossRef]
- Yang, T.; Xin, Y.; Zhang, L.; Gu, Z.; Li, Y.; Ding, Z.; Shi, G. Characterization on the aerobic denitrification process of Bacillus strains. Biomass Bioenerg. 2020, 140, 105677. [Google Scholar] [CrossRef]
- Ruan, Y.; Awasthi, M.K.; Cai, L.; Lu, H.; Xu, X.; Li, W. Simultaneous aerobic denitrification and antibiotics degradation by strain Marinobacter hydrocarbonoclasticus RAD-2. Bioresour. Technol. 2020, 313, 123609. [Google Scholar] [CrossRef]
- Zhang, W.; Yan, C.; Shen, J.; Wei, R.; Gao, Y.; Miao, A.; Xiao, L.; Yang, L. Characterization of aerobic denitrifying bacterium Pseudomonas mendocina strain GL6 and its potential application in wastewater treatment plant effluent. Int. J. Environ. Res. Public Health 2019, 16, 364. [Google Scholar] [CrossRef] [PubMed] [Green Version]
- Braker, G.; Zhou, J.; Wu, L.; Devol, A.H.; Tiedje, J.M. Nitrite reductase genes (nirK and nirS) as functional markers to investigate diversity of denitrifying bacteria in pacific northwest marine sediment communities. Appl. Environ. Microbiol. 2000, 66, 2096–2104. [Google Scholar] [CrossRef] [PubMed] [Green Version]
- Wang, X.; Wang, W.; Zhang, Y.; Sun, Z.; Zhang, J.; Chen, G.; Li, J. Simultaneous nitrification and denitrification by a novel isolated Pseudomonas sp. JQ-H3 using polycaprolactone as carbon source. Bioresour. Technol. 2019, 288, 121506. [Google Scholar] [CrossRef] [PubMed]
- Lei, X.; Jia, Y.; Chen, Y.; Hu, Y. Simultaneous nitrification and denitrification without nitrite accumulation by a novel isolated Ochrobactrum anthropic LJ81. Bioresour. Technol. 2018, 272, 442–450. [Google Scholar] [CrossRef]
- Zhao, B.; Cheng, D.Y.; Tan, P.; An, Q.; Guo, J.S. Characterization of an aerobic denitrifier Pseudomonas stutzeri strain XL-2 to achieve efficient nitrate removal. Bioresour. Technol. 2018, 250, 564–573. [Google Scholar] [CrossRef]
- Zhang, Y.; Wang, X.; Wang, W.; Sun, Z.; Li, J. Investigation of growth kinetics and partial denitrification performance in strain Acinetobacter johnsonii under different environmental conditions. Roy. Soc. Open Sci. 2019, 6, 191275. [Google Scholar] [CrossRef] [Green Version]
- Yang, M.; Lu, D.; Yang, J.; Zhao, Y.; Zhao, Q.; Sun, Y.; Liu, H.; Ma, J. Carbon and nitrogen metabolic pathways and interaction of cold-resistant heterotrophic nitrifying bacteria under aerobic and anaerobic conditions. Chemosphere 2019, 234, 162–170. [Google Scholar] [CrossRef]
- Xia, L.; Li, X.; Fan, W.; Wang, J. Heterotrophic nitrification and aerobic denitrification by a novel Acinetobacter sp. ND7 isolated from municipal activated sludge. Bioresour. Technol. 2020, 301, 122749. [Google Scholar] [CrossRef]
- Feng, Y.; Feng, J.; Shu, Q.L. Isolation and characterization of heterotrophic nitrifying and aerobic denitrifying Klebsiella pneumoniae and Klebsiella variicola strains from various environments. J. Appl. Microbiol. 2018, 124, 1195–1211. [Google Scholar] [CrossRef]
- Ye, Q.; Li, K.; Li, Z.; Yi, X.; He, T.; Tang, W.; Xiang, S. Heterotrophic nitrification-aerobic denitrification performance of strain Y-12 under low temperature and high concentration of inorganic nitrogen conditions. Water 2017, 9, 835. [Google Scholar] [CrossRef] [Green Version]
- Deng, M.; Zhao, X.; Senbati, Y.; Song, K.; He, X. Nitrogen removal by heterotrophic nitrifying and aerobic denitrifying bacterium Pseudomonas sp. DM02: Removal performance, mechanism and immobilized application for real aquaculture wastewater treatment. Bioresour. Technol. 2021, 322, 124555. [Google Scholar] [CrossRef] [PubMed]
- Zhang, M.; Li, A.; Yao, Q.; Wu, Q.; Zhu, H. Nitrogen removal characteristics of a versatile heterotrophic nitrifying-aerobic denitrifying bacterium, Pseudomonas bauzanensis DN13-1, isolated from deep-sea sediment. Bioresour. Technol. 2020, 305, 122626. [Google Scholar] [CrossRef] [PubMed]
- Xie, F.; Thiri, M.; Wang, H. Simultaneous heterotrophic nitrification and aerobic denitrification by a novel isolated Pseudomonas mendocina X49. Bioresour. Technol. 2020, 319, 124198. [Google Scholar] [CrossRef] [PubMed]
- Sun, Y.; Li, A.; Zhang, X.; Ma, F. Regulation of dissolved oxygen from accumulated nitrite during the heterotrophic nitrification and aerobic denitrification of Pseudomonas stutzeri T13. Appl. Microbiol. Biotechnol. 2015, 99, 3243–3248. [Google Scholar] [CrossRef]
- Man, Q.; Zhang, P.; Huang, W.; Zhu, Q.; He, X.; Wei, D. A heterotrophic nitrification-aerobic denitrification bacterium Halomonas venusta TJPU05 suitable for nitrogen removal from high-salinity wastewater. Front. Env. Sci. Eng. 2022, 16, 69. [Google Scholar] [CrossRef]
- Idi, A.; Ibrahim, Z.; Mohamad, S.E.; Majid, Z.A. Biokinetics of nitrogen removal at high concentrations by Rhodobacter sphaeroides ADZ101. Int. Biodeter. Biodegr. 2015, 105, 245–251. [Google Scholar] [CrossRef]
- Lang, X.; Li, Q.; Ji, M.; Yan, G.; Guo, S. Isolation and niche characteristics in simultaneous nitrification and denitrification application of an aerobic denitrifier, Acinetobacter sp. YS2. Bioresour. Technol. 2020, 302, 122799. [Google Scholar] [CrossRef]
- Ren, J.; Bai, X.; Liu, Y.; Huang, X. Simultaneous nitrification and aerobic denitrification by a novel isolated Ochrobactrum anthropi HND19. Bioresour. Technol. 2021, 340, 125582. [Google Scholar] [CrossRef]
- Ruan, Y.; Taherzadeh, M.J.; Kong, D.; Lu, H.; Zhao, H.; Xu, X.; Liu, Y.; Cai, L. Nitrogen removal performance and metabolic pathways analysis of a novel aerobic denitrifying halotolerant Pseudomonas balearica strain RAD-17. Microorganisms 2020, 8, 72. [Google Scholar] [CrossRef] [Green Version]
- Li, Y.; Wang, Y.; Fu, L.; Gao, Y.; Zhao, H.; Zhou, W. Aerobic-heterotrophic nitrogen removal through nitrate reduction and ammonium assimilation by marine bacterium Vibrio sp. Y1-5. Bioresour. Technol. 2017, 230, 103–111. [Google Scholar] [CrossRef]
- Wang, H.; Chen, N.; Feng, C.; Deng, Y. Insights into heterotrophic denitrification diversity in wastewater treatment systems: Progress and future prospects based on different carbon sources. Sci. Total Environ. 2021, 780, 146521. [Google Scholar] [CrossRef] [PubMed]
- Li, C.; Yang, J.; Wang, X.; Wang, E.; Li, B.; He, R.; Yuan, H. Removal of nitrogen by heterotrophic nitrification–aerobic denitrification of a phosphate accumulating bacterium Pseudomonas stutzeri YG-24. Bioresour. Technol. 2015, 182, 18–25. [Google Scholar] [CrossRef] [PubMed]
- Guo, L.; Chen, Q.; Fang, F.; Hu, Z.; Wu, J.; Miao, A.; Xiao, L.; Chen, X.; Yang, L. Application potential of a newly isolated indigenous aerobic denitrifier for nitrate and ammonium removal of eutrophic lake water. Bioresour. Technol. 2013, 142, 45–51. [Google Scholar] [CrossRef]
- Shu, H.; Sun, H.; Huang, W.; Zhao, Y.; Ma, Y.; Chen, W.; Sun, Y.; Chen, X.; Zhong, P.; Yang, H.; et al. Nitrogen removal characteristics and potential application of the heterotrophic nitrifying-aerobic denitrifying bacteria Pseudomonas mendocina S16 and Enterobacter cloacae DS’5 isolated from aquaculture wastewater ponds. Bioresour. Technol. 2021, 345, 126541. [Google Scholar] [CrossRef] [PubMed]
- Wen, G.; Wang, T.; Li, K.; Wang, H.; Wang, J.; Huang, T. Aerobic denitrification performance of strain Acinetobacter johnsonii WGX-9 using different natural organic matter as carbon source: Effect of molecular weight. Water Res. 2019, 164, 114956. [Google Scholar] [CrossRef] [PubMed]
- Lei, Y.; Wang, Y.; Liu, H.; Xi, C.; Song, L. A novel heterotrophic nitrifying and aerobic denitrifying bacterium, Zobellella taiwanensis DN-7, can remove high-strength ammonium. Appl. Microbiol. Biotechnol. 2016, 100, 4219–4229. [Google Scholar] [CrossRef]
- Fu, W.; Wang, Q.; Chen, S.; Wang, Y.; Wang, Y.; Duan, P.; Yi, G.; Liu, C.; Zhang, X.; Rao, Z. Isolation and identification of an efficient aerobic denitrifying Pseudomonas stutzeri strain and characterization of its nitrite degradation. Catalysts 2021, 11, 1214. [Google Scholar] [CrossRef]
- Zhao, K.; Tian, X.; Li, H.; Dong, S.; Jiang, W. Characterization of a novel marine origin aerobic nitrifying–denitrifying bacterium isolated from shrimp culture ponds. Aquac. Res. 2019, 50, 1770–1781. [Google Scholar] [CrossRef]
- Liu, Y.; Ai, G.-M.; Miao, L.-L.; Liu, Z.-P. Marinobacter strain NNA5, a newly isolated and highly efficient aerobic denitrifier with zero N2O emission. Bioresour. Technol. 2016, 206, 9–15. [Google Scholar] [CrossRef]
- Yang, L.; Wang, X.-H.; Cui, S.; Ren, Y.-X.; Yu, J.; Chen, N.; Xiao, Q.; Guo, L.-K.; Wang, R.-H. Simultaneous removal of nitrogen and phosphorous by heterotrophic nitrification-aerobic denitrification of a metal resistant bacterium Pseudomonas putida strain NP5. Bioresour. Technol. 2019, 285, 121360. [Google Scholar] [CrossRef]
- Kim, M.; Jeong, S.-Y.; Yoon, S.J.; Cho, S.J.; Kim, Y.H.; Kim, M.J.; Ryu, E.Y.; Lee, S.-J. Aerobic denitrification of Pseudomonas putida AD-21 at different C/N ratios. J. Biosci. Bioeng. 2008, 106, 498–502. [Google Scholar] [CrossRef] [PubMed]
- Ren, Y.-X.; Yang, L.; Liang, X. The characteristics of a novel heterotrophic nitrifying and aerobic denitrifying bacterium, Acinetobacter junii YB. Bioresour. Technol. 2014, 171, 1–9. [Google Scholar] [CrossRef] [PubMed]
- Timmermans, P.; van Haute, A. Denitrification with methanol-fundamental study of the growth and denitrification capacity of Hyphomicrobium spp. Water Res. 1983, 17, 1249–1255. [Google Scholar] [CrossRef]
- Fan, Y.; Su, J.; Zheng, Z.; Gao, J.; Ali, A. Denitrification performance and mechanism of a novel isolated Acinetobacter sp. FYF8 in oligotrophic ecosystem. Bioresour. Technol. 2021, 320, 124280. [Google Scholar] [CrossRef]
- Yang, J.-R.; Wang, Y.; Chen, H.; Lyu, Y.-K. Ammonium removal characteristics of an acid-resistant bacterium Acinetobacter sp. JR1 from pharmaceutical wastewater capable of heterotrophic nitrification-aerobic denitrification. Bioresour. Technol. 2019, 274, 56–64. [Google Scholar] [CrossRef]
- Ren, J.; Wei, C.; Ma, H.; Dai, M.; Fan, J.; Liu, Y.; Wu, Y.; Han, R. The nitrogen-removal efficiency of a novel high-efficiency salt-tolerant aerobic denitrifier, Halomonas alkaliphile hrl-9, isolated from a seawater biofilter. Int. J. Environ. Res. Public Health 2019, 16, 4451. [Google Scholar] [CrossRef] [Green Version]
- Ren, J.; Ma, H.; Liu, Y.; Ruan, Y.; Wei, C.; Song, J.; Wu, Y.; Han, R. Characterization of a novel marine aerobic denitrifier Vibrio spp. AD2 for efficient nitrate reduction without nitrite accumulation. Environ. Sci. Pollut. Res. 2021, 28, 30807–30820. [Google Scholar] [CrossRef]
- Ji, B.; Yang, K.; Zhu, L.; Jiang, Y.; Wang, H.; Zhou, J.; Zhang, H. Aerobic denitrification: A review of important advances of the last 30 years. Biotechnol. Bioproc. E. 2015, 20, 643–651. [Google Scholar] [CrossRef]
- Chen, S.; He, S.; Wu, C.; Du, D. Characteristics of heterotrophic nitrification and aerobic denitrification bacterium Acinetobacter sp. T1 and its application for pig farm wastewater treatment. J. Biosci. Bioeng. 2019, 127, 201–205. [Google Scholar] [CrossRef]
- Flemming, H.-C.; Wuertz, S. Bacteria and archaea on earth and their abundance in biofilms. Nat. Rev. Microbiol. 2019, 17, 247–260. [Google Scholar] [CrossRef]
- Zhang, J.; Miao, Y.; Zhang, Q.; Sun, Y.; Wu, L.; Peng, Y. Mechanism of stable sewage nitrogen removal in a partial nitrification-anammox biofilm system at low temperatures: Microbial community and EPS analysis. Bioresour. Technol. 2020, 297, 122459. [Google Scholar] [CrossRef] [PubMed]
- Dairawan, M.; Shetty, P.J. The evolution of DNA extraction methods. Am. J. Biomed. Sci. 2020, 8, 39–46. [Google Scholar] [CrossRef]
- Weisburg, W.G.; Barns, S.M.; Pelletier, D.A.; Lane, D.J. 16S ribosomal DNA amplification for phylogenetic study. J. Bacteriol. 1991, 173, 697–703. [Google Scholar] [CrossRef] [PubMed] [Green Version]
- Zhang, N.; Zhang, Y.; Bohu, T.; Wu, S.; Bai, Z.; Zhuang, X. Nitrogen removal characteristics and constraints of an alphaproteobacteria with potential for high nitrogen content heterotrophic nitrification-aerobic denitrification. Microorganisms 2022, 10, 235. [Google Scholar] [CrossRef]
Publisher’s Note: MDPI stays neutral with regard to jurisdictional claims in published maps and institutional affiliations. |
© 2022 by the authors. Licensee MDPI, Basel, Switzerland. This article is an open access article distributed under the terms and conditions of the Creative Commons Attribution (CC BY) license (https://creativecommons.org/licenses/by/4.0/).









